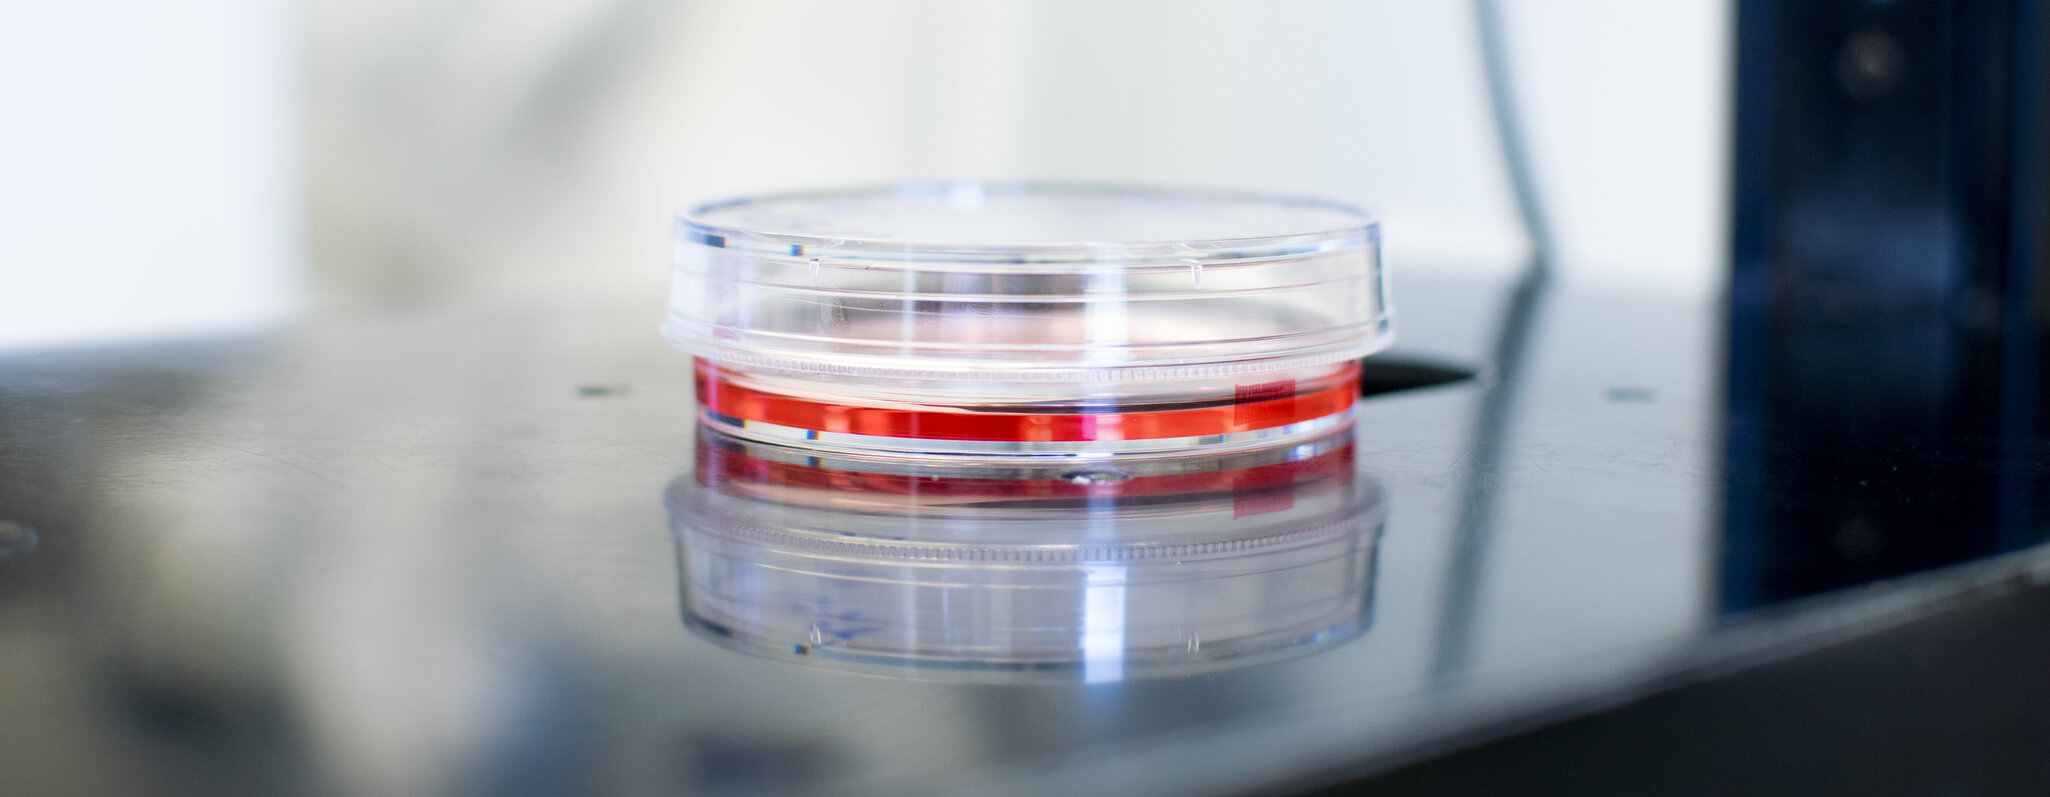
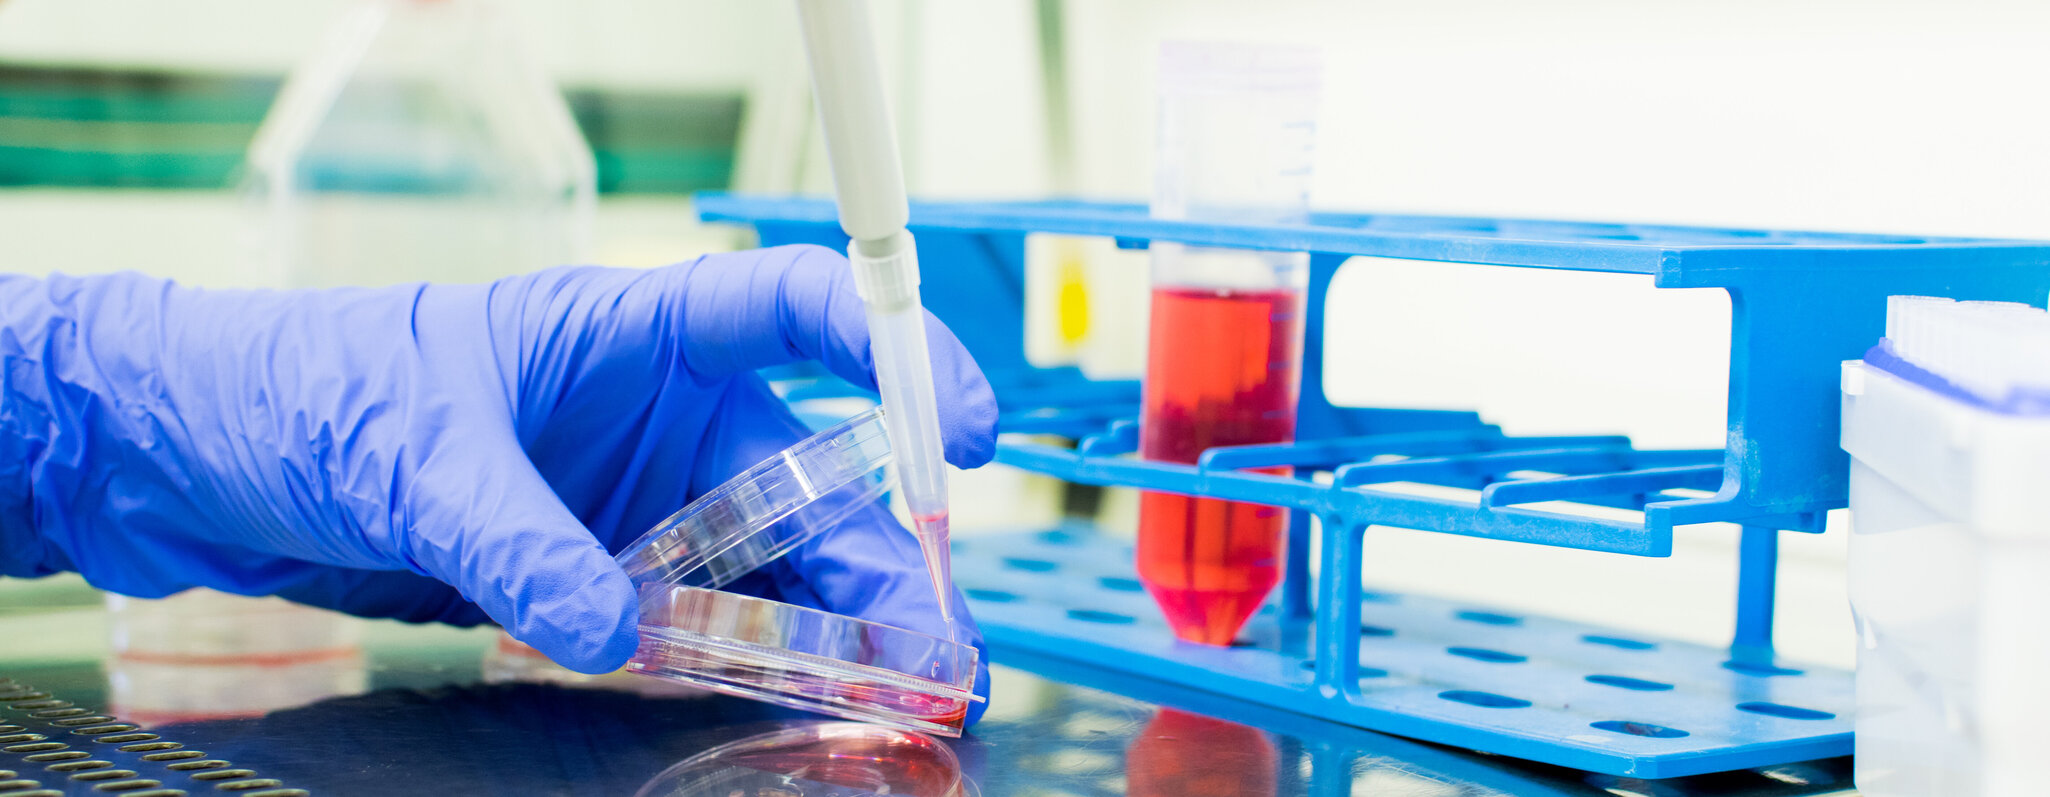

Das José Carreras Institut für Immun- und Gentherapie ist ein translationales Forschungslabor der Klinik für Innere Medizin I am Universitätsklinikum des Saarlandes in Homburg (Saar).
Forschung in der Klinik für Innere Medizin I am UKS
Die umfangreiche Expertise unseres Teams zeichnet unsere Klinik der Inneren Medizin I am UKS seit vielen Jahren aus.
Hervorzuheben sind in diesem Zusammenhang unsere intensiven Forschungsbemühungen, um das Verständnis und die Behandlungen für Lymphdrüsen- und Immunsystemerkrankungen kontinuierlich zu verbessern. Zu diesem Zweck arbeiten wir eng mit dem José-Carrera-Forschungszentrum zusammen.
Neben den zahlreichen klinischen Studien an den wir teilnehmen, entwickeln wir am Standort Homburg eigene Forschungskonzepte.
Unsere Studienzentrale leitet seit 1993 nationale und unternationale klinischen Studien im Rahmen der ehemaligen Deutsche Studiengruppe für hochmaligne Non-Hodgkin Lymphome (DSHNHL), aktuell GLA (German Lymphoma Alliance). Die Ergebnisse dieser Studien haben die aktuelle Behandlung von aggressiven Lymphdrüsenkrebs maßgeblich beeinflusst.
Im Rahmen der ersten Studiengeneration wurde in einer prospektiven, randomisierten Phase III - Studie (NHL-B1 / NHL-B2) mit 1697 Patienten geprüft, ob mittels einer Dosisintensivierung durch Verkürzung des Zeitintervalls oder durch Hinzunahme von Etoposid zur Standard-CHOP-Therapie eine Verbesserung der Therapieergebnisse erreicht werden kann.
Im Jahr 2000 wurde die 2. Studiengeneration begonnen und mehrere prospektive, randomisierte Phase III - Studien für die verschiedenen Risikogruppen gestartet, welche auf den Erfahrungen der ersten Studiengeneration aufbauten. Eine davon ist die internationale MInT-Studie, an der sich 172 Zentren aus 18 Ländern beteiligten. Diese internationale Studie konnte für die jungen Niedrigrisiko-patienten durch den Einsatz des monoklonalen Antikörpers Rituximab eine Verbesserung der Therapieergebnisse zeigen. Auch für Patienten über 60 Jahre konnte der Vorteil des Rituximab in der RICOVER-60-Studie eindrucksvoll demonstriert werden.
Die internationale Phase III FLYER Studie konnte belegen, dass eine Reduktion der Therapiezyklen von 6 auf 4 bei niedrig-risiko jungen Patienten gleichwertig ist und mit weniger Toxizität einhergeht. Hierdurch konnte international ein neuer Standard für diese Patienten etabliert werden.
Aktuell sind drei prospektive, internationale, Phase III Studien aktiv:
- OPTIMAL: Diese faktorielle 2 x 2-armige offene, multizentrische, prospektive, internationale randomisierte Phase-III-Studie untersucht,
- ob die Therapieergebnisse von älteren Patienten mit nicht vorbehandeltem aggressivem B-Zell Lymphom durch ein optimiertes Rituximab Schema verbessert werden können.
- ob die Therapiezyklen bei älteren Patienten mit nicht vorbehandeltem aggressivem B-Zell Lymphom und niedrig-risiko Erkrankung von 6 auf 4 reduziert werden können.
- ob die Therapieergebnisse von älteren Patienten mit nicht vorbehandeltem aggressivem B-Zell Lymphom durch liposomales Vincristin verbessert werden können.
- NIVEAU: Diese offene, multizentrische, prospektive, internationale Phase-III-Studie untersucht, ob die Therapieergebnisse von älteren Patienten mit Rezidiv eines aggressiven B- oder T-Zell Lymphoms, die für eine Stammzelltransplantation nicht in Frage kommen, durch die Hinzunahme des Immuntherapeutikums Nivolumab verbessert werden können.
- ARCHED: Diese offene, multizentrische, prospektive, internationale Phase-III-Studie untersucht, ob die Therapieergebnisse von älteren Patienten mit nicht vorbehandeltem aggressivem B-Zell Lymphom, die eine volldosierte Chemotherapie nicht vertragen können, durch die Hinzunahme des zielgerichteten BTK Inhibitors der zweiten Generation Acalabrutinib verbessert werden können.
Weiterführende Informationen zu unserer Forschung erhalten Sie unter: